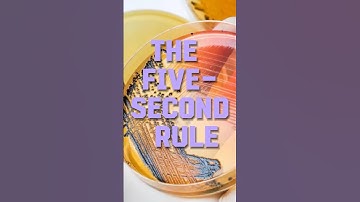
Is the Five-Second Rule a Myth? Debunked in 60 Seconds!

⬇ DOWNLOAD NOW
Kalau muncul iklan pop-up, tutup lalu klik tombol kembali
Download lagu 5-Second Rule | Truth or Myth?🤔 secara gratis hanya untuk keperluan promosi. Dukung artis favorit kamu dengan membeli musik original di iTunes atau platform resmi lainnya.
 Drop It Like It's Hot! Is The Five Second Rule Correct? | MythBusters
Drop It Like It's Hot! Is The Five Second Rule Correct? | MythBusters
 Mythbusters - 5 second Rule
Mythbusters - 5 second Rule
 DIY Science: Is the 5-second rule true?
DIY Science: Is the 5-second rule true?
 Is The 5-Second Rule True?
Is The 5-Second Rule True?
 The Myth of the Five-Second Rule
The Myth of the Five-Second Rule
 Is The 5 Second Rule Actually Real?
Is The 5 Second Rule Actually Real?
Is the Five-Second Rule a Myth? Debunked in 60 Seconds!
Is the Five-Second Rule a Myth? Debunked in 60 Seconds!
 The Myth of the Five Second Rule
The Myth of the Five Second Rule